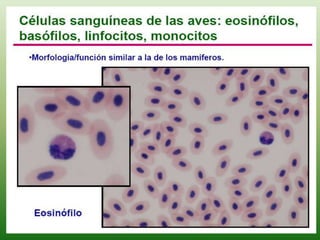
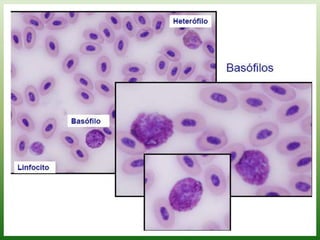
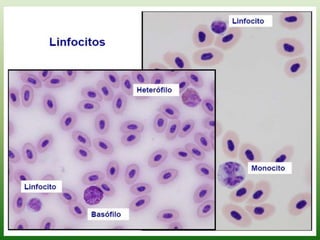

Este documento resume el sistema cardiovascular de las aves. Describe que las aves tienen un corazón de cuatro cámaras como los mamíferos, pero que sus glóbulos rojos contienen núcleo. Explica las funciones básicas del sistema como transporte de oxígeno y nutrientes. También describe los componentes principales como el corazón, vasos sanguíneos, y tipos de células en la sangre como eritrocitos y leucocitos.